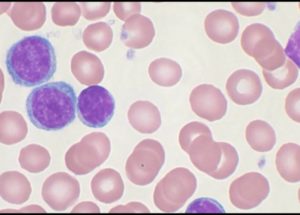
A Protein That Marks Cancer Cells Has Just Been Discovered

iFR to be More Useful than FFR for Patients who need PCI
While non-obtrusive prompt wave-free ratio (iFR) and fractional flow reserve (FFR) are both practical and effectual in plan the blockages, iFR has appeared to be considerably more cost-effective. To what extent is this true? The utilization of IFR can supposedly…